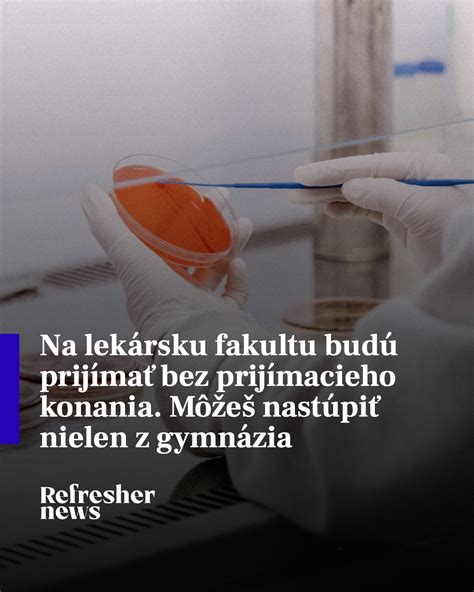
Ilustrácia prijímacieho konania na lekársku fakultu

Jesseniova lekárska fakulta Univerzity Komenského v Bratislave (JLF UK) v Martine je významnou vzdelávacou a výskumnou inštitúciou v oblasti medicíny na Slovensku. Fakulta poskytuje vzdelanie v študijných programoch všeobecné lekárstvo a zubné lekárstvo, a to v slovenskom aj anglickom jazyku. Okrem vysokoškolského štúdia sa fakulta venuje aj ďalšiemu vzdelávaniu lekárov, ako sú špecializačné štúdium a rigorózne konanie.
Študijné programy a prijímacie konanie
Na bakalárske štúdium v dennej forme je základnou podmienkou prijatia získanie úplného stredného vzdelania alebo úplného stredného odborného vzdelania a zdravotná spôsobilosť na výkon povolania. Prijímacie konanie na štúdium všeobecného lekárstva a zubného lekárstva zahŕňa online test z predmetov chémia a biológia. Kritériom pre prijatie je celkový bodový zisk z prijímacej skúšky.
Uchádzač o štúdium uhradí poplatok za prijímacie konanie bankovým prevodom alebo poštovým peňažným poukazom. Doklad o zaplatení je potrebné priložiť k elektronickej prihláške. V prípade neúčasti na prijímacej skúške sa poplatok nevracia.
Súčasťou prihlášky pre všetkých uchádzačov je potvrdenie o zdravotnej spôsobilosti na štúdium potvrdené všeobecným lekárom a kópia pasu alebo iného ID pre overenie totožnosti. Uchádzači, ktorí ukončili stredoškolské štúdium na školách v zahraničí, predložia doklad o rovnocennosti alebo nostrifikačnú doložku. Uchádzač so špecifickými potrebami, ktorý požaduje primerané úpravy pri prijímacej skúške, posiela spolu s prihláškou aj žiadosť o prispôsobenie formy prijímacej skúšky.
Školné a poplatky
Štandardná dĺžka štúdia všeobecného lekárstva v anglickom jazyku je spojená so školným vo výške 11500 €. Rovnaká výška školného platí aj pre štúdium dlhšie ako je štandardná dĺžka alebo súbežné štúdium. Školné je potrebné zaplatiť pred začiatkom semestra.
Vzorové informácie o platbe školného:
| Typ platby | Banka príjemcu | SWIFT/BIC | Číslo účtu (IBAN) | Názov účtu príjemcu | Adresa príjemcu | Informácie pre príjemcu |
|---|---|---|---|---|---|---|
| KRAJINY SEPA | Štátna pokladnica | SPSRSKBAXXX | SK10 8180 0000 0070 0024 4103 | Jesseniova lekárska fakulta v Martine UK v Bratislave | Šafárikovo námestie 6, P.O. BOX 44, 0814 99 Bratislava, Slovensko | meno študenta, ročník štúdia, školné |
| KRAJINY MIMO SEPA | Štátna pokladnica | SPSRSKBAXXX | SK10 8180 0000 0070 0024 4103 | Jesseniova lekárska fakulta v Martine UK v Bratislave | Šafárikovo námestie 6, P.O. BOX 44, 0814 99 Bratislava, Slovensko | meno študenta, ročník štúdia, školné |
Každý študent je povinný pri zápise na príslušný akademický rok predložiť kópiu bankového dokladu o úhrade školného v plnej výške. Na bankovom doklade musí byť uvedené meno študenta.

Lekárske potvrdenia a ďalšie štúdium
V kontexte štúdia na lekárskej fakulte sa často vyskytuje potreba lekárskych potvrdení, najmä pri prijímacom konaní či pri štúdiu samotnom. Je dôležité zdôrazniť, že prihláška na štúdium na JLF UK Martin vyžaduje potvrdenie o zdravotnej spôsobilosti na štúdium, ktoré potvrdzuje všeobecný lekár.
Fakulta tiež poskytuje možnosti ďalšieho vzdelávania pre lekárov. Súčasťou týchto možností je aj špecializačné štúdium, kde sú informácie o študijnom programe pravidelne zverejňované. Školiteľom v rámci špecializačného štúdia môže byť zdravotnícky pracovník s príslušnou odbornou spôsobilosťou.
Pre zdravotnícke povolania lekár a zubný lekár existuje možnosť vykonania doplňujúcej skúšky, ktorá sa realizuje v súlade so zákonmi a vyhláškami. Na prípravu na tieto skúšky fakulta pripravila súbor vybraných prednášok formou zdieľaných videí. Neúčasť na doplňujúcej skúške je možné ospravedlniť len na základe lekárskeho potvrdenia.
Absolvovaním študijného programu lekárskej fakulty získava absolvent odbornú spôsobilosť na výkon profesie všeobecný lekár, ako aj na ďalšie špecializačné a certifikačné štúdium. Absolventi sú spôsobilí pracovať a skúmať v danom odbore a celoživotne sa vzdelávať. Ovládajú základy medicíny, lekárskeho vyšetrovania a diagnostiky, ako aj základy poskytovania kvalifikovanej pomoci v život ohrozujúcich stavoch. Sú pripravení na pôsobenie v primárnej zdravotníckej starostlivosti a získajú predpoklady pre špecializáciu alebo uplatnenie v medicínskom výskume.

Informácie o súboroch cookie a ich správe sú dôležité pre používateľov internetových stránok fakulty. Tieto súbory cookie môžu ovplyvniť používateľskú skúsenosť a služby, ktoré fakulta ponúka. Používatelia si môžu v nastaveniach vybrať, ktoré typy súborov cookie nepovolia, pričom je potrebné uvedomiť si, že blokovanie niektorých súborov cookie môže ovplyvniť funkčnosť stránky.
tags: #lekarska #fakulta #martin #lekarske #potvrdenie